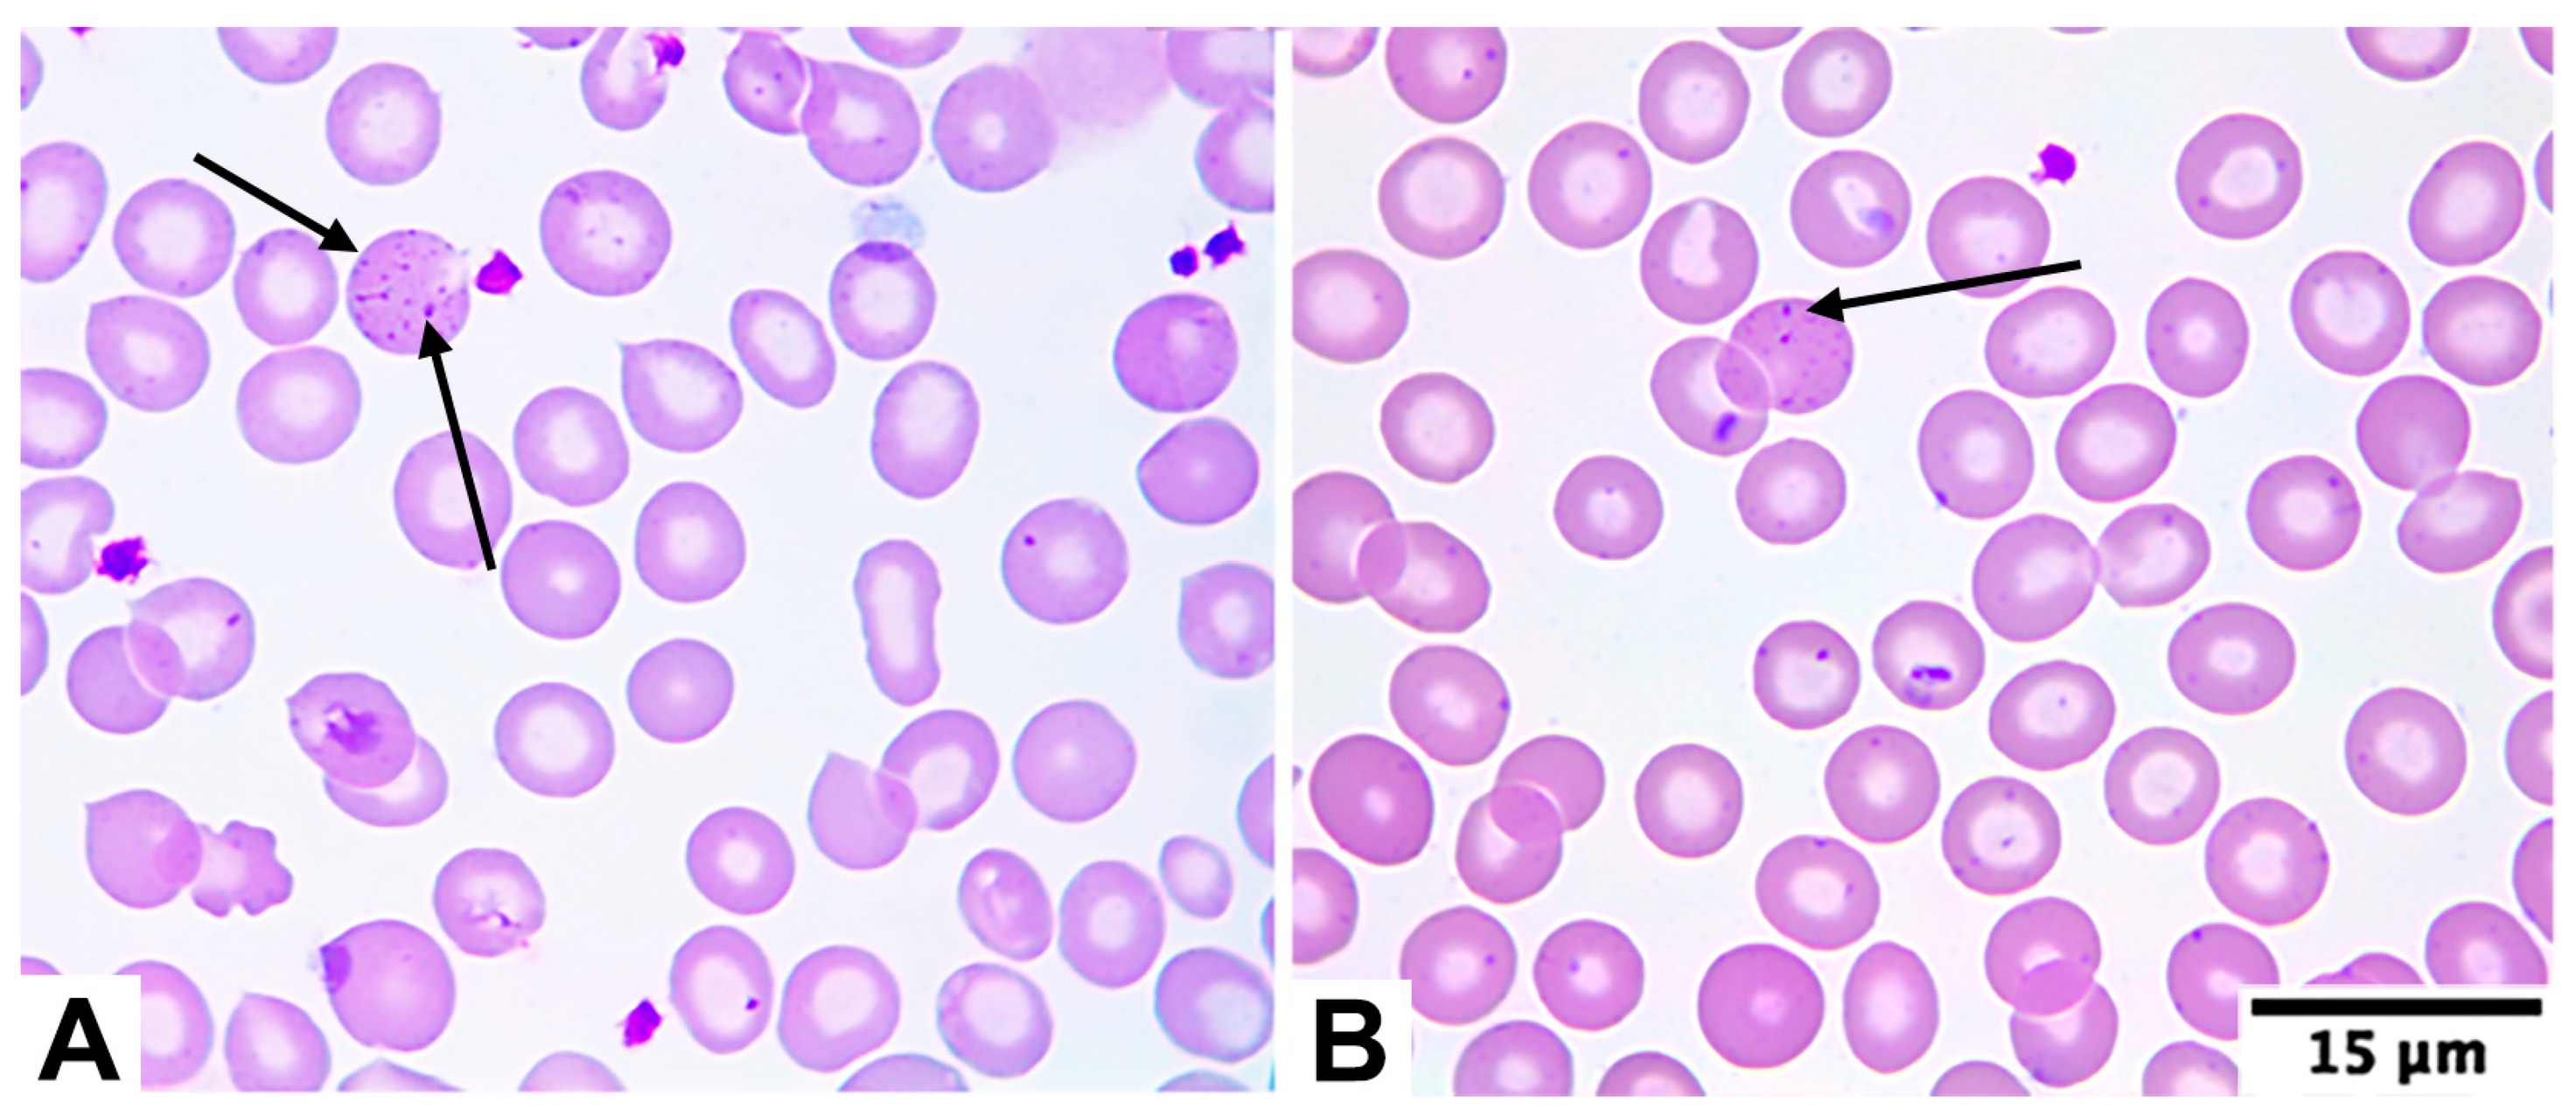
Diagnostics 15 02759 g001 Diagnostics 15 02759 g001

Assessment of β-Thalassemia Trait Occurrence in an Outpatient Sample from Southern Chile: A Retrospective Study
Abstract
1. Introduction
2. Materials and Methods
3. Results
4. Discussion
4.1. South American Comparison
4.2. Hematological Phenotype
4.3. Morphological Characteristics
4.4. Clinical Implications
4.5. Public Health Implications
4.6. Limitations
5. Conclusions
Author Contributions
Funding
Institutional Review Board Statement
Informed Consent Statement
Data Availability Statement
Conflicts of Interest
References
- Benz, E.J. Introduction to the thalassemia syndromes: Molecular medicine’s index case. Hematol. Clin. 2023, 37, 245–259. [Google Scholar] [CrossRef]
- Tuo, Y.; Li, Y.; Li, Y.; Ma, J.; Yang, X.; Wu, S.; Jin, J.; He, Z. Global, regional, and national burden of thalassemia, 1990–2021: A systematic analysis for the global burden of disease study 2021. eClinicalMedicine 2024, 72, 102619. [Google Scholar] [CrossRef]
- Sadiq, I.Z.; Abubakar, F.S.; Usman, H.S.; Abdullahi, A.D.; Ibrahim, B.; Kastayal, B.S.; Ibrahim, M.; Hassan, H.A. Thalassemia: Pathophysiology, diagnosis, and advances in treatment. Thalass. Rep. 2024, 14, 81–102. [Google Scholar] [CrossRef]
- Ali, S.; Mumtaz, S.; Shakir, H.A.; Khan, M.; Tahir, H.M.; Mumtaz, S.; Mughal, T.A.; Hassan, A.; Kazmi, S.A.R.; Sadia; et al. Current status of beta-thalassemia and its treatment strategies. Mol. Genet. Genomic Med. 2021, 9, e1788. [Google Scholar] [CrossRef]
- Galanello, R.; Cao, A. Gene test review: Alpha-thalassemia. Genet. Med. 2011, 13, 83–88. [Google Scholar] [CrossRef] [PubMed]
- Weatherall, D.J. Phenotype–genotype relationships in monogenic disease: Lessons from the thalassemias. Nat. Rev. Genet. 2001, 2, 245–255. [Google Scholar] [CrossRef] [PubMed]
- Piel, F.B.; Weatherall, D.J. The alpha-thalassemias. N. Engl. J. Med. 2014, 371, 1908–1916. [Google Scholar] [CrossRef] [PubMed]
- Harteveld, C.L.; Higgs, D.R. α-thalassaemia. Orphanet J. Rare Dis. 2010, 5, 13. [Google Scholar] [CrossRef]
- Jaing, T.H.; Chang, T.Y.; Chen, S.H.; Lin, C.W.; Wen, Y.C.; Chiu, C.C. Molecular genetics of β-thalassemia: A narrative review. Medicine 2021, 100, e27522. [Google Scholar] [CrossRef]
- Nienhuis, A.W.; Nathan, D.G. Pathophysiology and clinical manifestations of the β-thalassemias. Cold Spring Harb. Perspect. Med. 2012, 2, a011726. [Google Scholar] [CrossRef]
- Mettananda, S.; Gibbons, R.J.; Higgs, D.R. α-Globin as a molecular target in the treatment of β-thalassemia. Blood 2015, 125, 3694–3701. [Google Scholar] [CrossRef]
- d’Arqom, A. Nucleic acid therapy for β-thalassemia. Biologics 2020, 14, 95–105. [Google Scholar] [CrossRef]
- Modell, B.; Khan, M.; Darlison, M.; Westwood, M.A.; Ingram, D.; Pennell, D.J. Improved survival of thalassaemia major in the UK and relation to T2* cardiovascular magnetic resonance. J. Cardiovasc. Magn. Reson. 2008, 10, 42. [Google Scholar] [CrossRef]
- Galanello, R.; Origa, R. Beta-thalassemia. Orphanet J. Rare Dis. 2010, 5, 11. [Google Scholar] [CrossRef]
- Vichinsky, E.P. Changing patterns of thalassemia worldwide. Ann. N. Y. Acad. Sci. 2005, 1054, 18–24. [Google Scholar] [CrossRef] [PubMed]
- Kattamis, A.; Forni, G.L.; Aydinok, Y.; Viprakasit, V. Changing patterns in the epidemiology of β-thalassemia. Eur. J. Haematol. 2020, 105, 692–703. [Google Scholar] [CrossRef] [PubMed]
- Hedrick, P.W. Population genetics of malaria resistance in humans. Heredity 2011, 107, 283–304. [Google Scholar] [CrossRef]
- Rao, E.; Kumar Chandraker, S.; Singh, M.; Kumar, R. Global distribution of β-thalassemia mutations: An update. Gene 2024, 896, 148022. [Google Scholar] [CrossRef] [PubMed]
- Vargas-Hernández, D.; Uscategui-Ruiz, A.; De Avila, J.; Romero-Sánchez, C. Differences in the distribution of hemoglobin variants according to the geographic regions in a Colombian population. Hematol. Transfus. Cell Ther. 2023, 45, S140–S147. [Google Scholar] [CrossRef]
- Rosenfeld, L.; Bacal, N.; Cuder, M.; Silva, A.; Machado, Í.; Pereira, C.; Souza, M.; Malta, D. Prevalence of hemoglobinopathies in the Brazilian adult population: National Health Survey 2014–2015. Rev. Bras. Epidemiol. 2019, 22, e190007.supl.2. [Google Scholar] [CrossRef]
- Salas-Wright, C.; Maldonado-Molina, M.; Pérez-Gómez, A.; Trujillo, J.M.; Schwartz, S.J. The Venezuelan diaspora: Migration-related experiences and mental health. Curr. Opin. Psychol. 2022, 47, 101430. [Google Scholar] [CrossRef]
- Ruiz-Argüelles, G.; López-Martínez, B.; Ruiz-Reyes, G. Heterozygous beta-thalassemia: Not infrequent in Mexico. Arch. Med. Res. 2001, 32, 293–295. [Google Scholar] [CrossRef]
- Evans, G.; Poulsen, R.; Canahuate, J.; Pastor, J. Talasemia asociada a embarazo. Rev. Chil. Obstet. Ginecol. 2003, 68, 124–128. [Google Scholar] [CrossRef]
- Díaz, A.; Urrutia, M.; Roos, A.; Lagos, G. Talasemia y embarazo: Caso clínico y revisión de la literatura. Rev. Obstet. Ginecol. Hosp. Santiago Oriente “Dr. Luis Tisné Brousse” 2009, 4, 42–45. [Google Scholar]
- Game, L.; Bergounioux, J.; Close, J.P.; Marzouka, B.E.; Thein, S.L. A novel deletion causing (εγδβ)0 thalassaemia in a Chilean family. Br. J. Haematol. 2003, 123, 154–159. [Google Scholar] [CrossRef]
- Cid, F.; Vargas, J.; Bravo, P.; Cid, C.; Valdés, C.; Salazar, J.; Rojas, J.; Vallette, A.; Yévenes, K. Beta-talasemia menor durante el embarazo: Reporte de un caso. Rev. Chil. Estud. Med. 2016, 9, 589–594. [Google Scholar] [CrossRef]
- Ceresa, S.; Daiber, A.; González, E. Beta talasemia mayor en un niño chileno. Rev. Chil. Pediatr. 1976, 48, 243–246. [Google Scholar] [CrossRef]
- Balcázar, M.; Carrasco, L.; Mancilla, A.; Navia, S. Evaluación del rendimiento de 29 índices discriminatorios para la diferenciación presuntiva entre anemia ferropénica y beta talasemia menor. In Proceedings of the XXII Congreso Chileno de Hematología and XII Congreso de Medicina Transfusional, Virtual, Chile, 26–31 October 2021; p. 76. Available online: https://www.sochihem.cl/site/docs/libro_resumenes2021.pdf (accessed on 20 October 2025).
- Balcázar-Villarroel, M.; Mancilla-Uribe, A.; Navia-León, S.; Carmine, F.; Birditt, K.; Sandoval, C. Diagnostic performance of red blood cell indices in the differential diagnosis of iron deficiency anemia and the thalassemia trait in Chile: A retrospective study. Diagnostics 2024, 14, 2353. [Google Scholar] [CrossRef] [PubMed]
- Villagra, L. Determinación de la Frecuencia de Beta Talasemia en Población Atendida en el Laboratorio Clínico de Clínica Las Condes. Master’s Thesis, Universidad de Valparaíso, Valparaíso, Chile, 2014. (Unpublished Thesis). Available online: https://repositoriobibliotecas.uv.cl/items/07bba9b4-65d4-4243-aab5-b1d708aa182f (accessed on 20 October 2025).
- Stephens, A.; Angastiniotis, M.; Baysal, E.; Chan, V.; Fucharoen, S.; Giordano, P.; Hoyer, J.; Mosca, A.; Wild, B. International Council for the Standardisation of Haematology (ICSH). ICSH recommendations for the measurement of haemoglobin A2. Int. J. Lab. Hematol. 2012, 34, 1–13. [Google Scholar] [CrossRef]
- Jameel, T.; Baig, M.; Ahmed, I.; Hussain, M.B.; Alkhamaly, M.B.D. Differentiation of beta thalassemia trait from iron deficiency anemia by hematological indices. Pak. J. Med. Sci. 2017, 33, 665–669. [Google Scholar] [CrossRef] [PubMed]
- Zaghloul, A.; Al-bukhari, T.; Bajuaifer, N.; Shalaby, M.; ALPakistani, H.; Halawani, S.; Teama, S.; Wassif, G. Introduction of new formulas and evaluation of the previous red blood cell indices and formulas in the differentiation between beta thalassemia trait and iron deficiency anemia in the Makkah region. Hematology 2016, 21, 351–358. [Google Scholar] [CrossRef]
- de Benoist, B.; McLean, E.; Egli, I.; Cogswell, M. Worldwide Prevalence of Anaemia 1993–2005: WHO Global Database on Anaemia; WHO Press: Geneva, Switzerland, 2008; Available online: https://www.who.int/publications/i/item/9789241596657 (accessed on 20 October 2025).
- Palmer, L.; Briggs, C.; McFadden, S.; Zini, G.; Burthem, J.; Rozenberg, G.; Proytcheva, M.; Machin, S.J. ICSH recommendations for the standardization of nomenclature and grading of peripheral blood cell morphological features. Int. J. Lab. Hematol. 2015, 37, 287–303. [Google Scholar] [CrossRef]
- Thein, S.L. The molecular basis of β-thalassemia. Cold Spring Harb. Perspect. Med. 2013, 3, a011700. [Google Scholar] [CrossRef] [PubMed]
- Valko, J. Desmitificación del inmigrante alemán en Don Helmuth, el colono de Carlos Fuenzalida Valdivia. Acta Lit. 2010, 40, 45–69. [Google Scholar] [CrossRef]
- Kohne, E.; Kleihauer, E. Hemoglobinopathies: A longitudinal study over four decades. Dtsch. Arztebl. Int. 2010, 107, 65–71. [Google Scholar] [CrossRef]
- Perić Kaselj, M.; Kuti, S. Croatian immigrants in Chile. AEMI J. 2007, 5, 93–106. Available online: http://aemi.eu/wp-content/uploads/2012/09/2006-07-1.pdf (accessed on 20 October 2025).
- Efremov, G.D. Hemoglobinopathies in Yugoslavia: An update. Hemoglobin 1992, 16, 531–544. [Google Scholar] [CrossRef]
- Chiappe, G. Talasemias: Aspectos clínicos. Acta Bioquím. Clín. Latinoam. 2017, 51, 281–289. Available online: https://www.redalyc.org/pdf/535/53553013003.pdf (accessed on 20 October 2025).
- Arends, A.; Chacín, M.; Bravo-Urquiola, M.; Montilla, S.; Guevara, J.M.; Velásquez, D.; García, G.; Álvarez, M.; Castillo, O. Hemoglobinopatías en Venezuela. Interciencia 2007, 32, 516–521. Available online: http://ve.scielo.org/scielo.php?script=sci_arttext&pid=S0378-18442007000800006 (accessed on 20 October 2025).
- Castillo, J.; Hazan, E.; Márquez, M.; Estado actual de las hemoglobinopatías en el Perú. EsSalud Repositorio Digital, Premio Kaelin. 1997, pp.17–39. Available online: https://repositorio.essalud.gob.pe/handle/20.500.12959/4488 (accessed on 20 October 2025).
- Domínguez, Y.; Zurita, C.; Calvopiña, D.; Villacís, J.; Mora, M. Prevalence of common hemoglobin variants in an afro-descendent Ecuadorian population. BMC Res. Notes 2013, 6, 132. [Google Scholar] [CrossRef]
- Luz, J.D.; Avila, A.; Icasuriaga, S.; Góngora, M.; Castillo, L.; Serrón, A.; Kimura, E.; Costa, F.; Sans, M.; Sonati, M. Frequency and spectrum of hemoglobinopathy mutations in a Uruguayan pediatric population. Genet. Mol. Biol. 2013, 36, 316–322. [Google Scholar] [CrossRef]
- Servicio Nacional de Migraciones. Estimación de la Población Extranjera en Chile 2018; Instituto Nacional de Estadísticas Chile: Santiago, Chile, 2024. Available online: https://www.ine.gob.cl/docs/default-source/demografia-y-migracion/publicaciones-y-anuarios/migración-internacional/estimación-población-extranjera-en-chile-2018/informe-resultados-epe2023.pdf?sfvrsn=91b95f6f_10 (accessed on 20 October 2025).
- Laengsri, V.; Shoombuatong, W.; Adirojananon, W.; Nantasenamat, C.; Prachayasittikul, V.; Nuchnoi, P. ThalPred: A web-based prediction tool for discriminating thalassemia trait and iron deficiency anemia. BMC Med. Inform. Decis. Mak. 2019, 19, 212. [Google Scholar] [CrossRef]
- Grau, M.; Sánchez, R.; Fort, I.; Gutiérrez, C.; Sans, T. New haematologic score to discriminate beta thalassemia trait from iron deficiency anaemia in a Spanish Mediterranean region. Clin. Chim. Acta 2020, 507, 69–74. [Google Scholar] [CrossRef]
- Hoffmann, J.; Urrechaga, E.; Aguirre, U. Discriminant indices for distinguishing thalassemia and iron deficiency in patients with microcytic anemia: A meta-analysis. Clin. Chem. Lab. Med. 2015, 53, 1883–1894. [Google Scholar] [CrossRef]
- Kulkarni, P.; Masthi, N.; Niveditha, S.; Suvarna, R. The prevalence of the beta thalassemia trait among the pregnant women who attended the ANC clinic in a PHC, by using the NESTROF test in Bangalore, Karnataka. J. Clin. Diagn. Res. 2013, 7, 1414–1417. [Google Scholar] [CrossRef]
- Mazza, U.; Saglio, G.; Cappio, F.; Camaschella, C.; Neretto, G.; Gallo, E. Clinical and haematological data in 254 cases of beta-thalassaemia trait in Italy. Br. J. Haematol. 1976, 33, 91–99. [Google Scholar] [CrossRef] [PubMed]
- Wickramaratne, K.; Wijewickrama, D. Screening for beta-thalassemia trait: Applicability of red cell indices and parameters—A study in Sri Lanka. Int. J. Health Sci. 2021, 15, 29–34. [Google Scholar]
- Sari, D.; Wahidiyat, P.; Setianingsih, I.; Timan, I.; Gatot, D.; Kekalih, A. Hematological parameters in individuals with beta thalassemia trait in South Sumatra, Indonesia. Anemia 2022, 3572986. [Google Scholar] [CrossRef]
- Rund, D.; Filon, D.; Strauss, N.; Rachmilewitz, E.; Oppenheim, A. Mean corpuscular volume of heterozygotes for β-thalassemia correlates with the severity of mutations. Blood 1992, 79, 238–243. [Google Scholar] [CrossRef] [PubMed]
- Vayá, A.; Carratalá, A.; Martinez, C.; Aznar, J. Haematological and clinical data in 200 cases of thalassaemia trait in eastern Spain. Nouv. Rev. Fr. Hematol. 1983, 25, 369–373. [Google Scholar]
- Körber, C.; Wölfler, A.; Neubauer, M.; Robier, C. Red blood cell morphology in patients with β-thalassemia minor. Lab. Med. 2017, 41, 49–52. [Google Scholar] [CrossRef]
- Aixalá, M. Anemia microcítica-hipocrómica: Anemia ferropénica versus β talasemia menor. Acta Bioquím. Clín. Latinoam. 2017, 51, 291–305. Available online: https://www.scielo.org.ar/pdf/abcl/v51n3/v51n3a04.pdf (accessed on 20 October 2025).
- Lazarte, S.; de Nofal, M.; Agüero, M.; Issé, B. Perfil hematológico de la β-talasemia menor en Tucumán. Acta Bioquím. Clín. Latinoam. 2007, 41, 219–223. Available online: https://www.scielo.org.ar/pdf/abcl/v41n2/v41n2a05.pdf (accessed on 20 October 2025).
- Harrington, A.; Ward, J.; Kroft, S. Iron deficiency anemia, β-thalassemia minor, and anemia of chronic disease: A morphologic reappraisal. Am. J. Clin. Pathol. 2008, 129, 466–471. [Google Scholar] [CrossRef]
- Calero, F.; Villegas, A.; Porres, A.; Valverde, F.; del Potro, E.; Sánchez, P.; Luque, J.; Espinós, D. Hematologic data in 825 cases of beta-thalassemia trait in Spain. Nouv. Rev. Fr. Hematol. 1990, 32, 265–270. [Google Scholar]
- Schriever, H.G. Red cell indices in thalassemia minor. Ann. Clin. Lab. Sci. 1974, 4, 339–342. Available online: https://www.annclinlabsci.org/content/4/5/339.short (accessed on 20 October 2025). [PubMed]
- Cheson, B.; Rom, W.; Webber, R. Basophilic stippling of red blood cells: A nonspecific finding of multiple etiology. Am. J. Ind. Med. 1984, 5, 327–334. [Google Scholar] [CrossRef] [PubMed]
- Joishy, S.; Shafer, J.; Rowley, P. The contribution of red cell morphology to the diagnosis of beta-thalassemia trait. Blood Cells 1986, 11, 367–374. [Google Scholar]
- Sociedad Argentina de Hematología. Guías de Diagnóstico y Tratamiento; Eritropatías; Sociedad Argentina de Hematología: Buenos Aires, Argentina, 2023; Available online: https://sah.org.ar/docs/guias/2023/Eritropatias-Guia_2023-Libro.pdf (accessed on 20 October 2025).
- Hansen, R.; Hanson, G.; Anderson, T. Failure to Suspect and Diagnose Thalassemic Syndromes. Interpretation of RBC Indices by the Non-hematologist. Arch. Intern. Med. 1985, 145, 93–94. [Google Scholar] [CrossRef]
- Shalev, O.; Yehezkel, E.; Rachmilewitz, E. Inadequate Utilization of Routine Electronic RBC Counts to Identify Beta Thalassemia Carriers. Am. J. Public Health 1988, 78, 1476–1477. [Google Scholar] [CrossRef] [PubMed]
- Kakkar, N.; Kaur, R.; Sohi, I.; Wadhawan, R. Clinicians response to red cell parameters on automated blood counts indicative of thalassemia trait. J. Postgrad. Med. 2007, 53, 78–79. [Google Scholar] [CrossRef]
- Ruiz-Reyes, G. Los sindromes talasémicos no son infrecuentes en la población mexicana y se subdiagnostican y confunden con deficiencias de hierro. Med. Univ. 1999, 1, 67–73. [Google Scholar]
- Torrens, M. Interpretación clínica del hemograma. Rev. Med. Clin. Condes 2015, 26, 713–725. [Google Scholar] [CrossRef]
- Clark, B.; Thein, S. Molecular diagnosis of haemoglobin disorders. Clin. Lab. Haematol. 2004, 26, 159–176. [Google Scholar] [CrossRef]
- Green, R.; King, R. A new red cell discriminant incorporating volume dispersion for differentiating iron deficiency anemia from thalassemia minor. Blood Cells 1989, 15, 481–495. [Google Scholar]
- Urrechaga, E.; Hoffmann, J. Critical appraisal of discriminant formulas for distinguishing thalassemia from iron deficiency in patients with microcytic anemia. Clin. Chem. Lab. Med. 2017, 55, 1582–1591. [Google Scholar] [CrossRef]
- Urrechaga, E. Discriminant value of % microcytic/% hypochromic ratio in the differential diagnosis of microcytic anemia. Clin. Chem. Lab. Med. 2008, 46, 1752–1758. [Google Scholar] [CrossRef]
- Urrechaga, E.; Borque, L.; Escanero, J. The role of automated measurement of RBC subpopulations in differential diagnosis of microcytic anemia and β-thalassemia screening. Am. J. Clin. Pathol. 2011, 135, 374–379. [Google Scholar] [CrossRef]
- Velasco-Rodríguez, D.; Alonso-Domínguez, J.; González-Fernández, F.; Villarrubia, J.; Ropero, P.; Martínez-Nieto, J.; de la Fuente, F.; Guillén, R.; Acedo, N.; Serí, C.; et al. δβ-thalassemia trait: How can we discriminate it from β-thalassemia trait and iron deficiency anemia? Am. J. Clin. Pathol. 2014, 142, 567–573. [Google Scholar] [CrossRef] [PubMed]
- Noguera, N.; Bragós, I.; Milani, A. Prevalence of -α3.7-thalassemia in Argentina. Hemoglobin 2002, 26, 103–106. [Google Scholar] [CrossRef] [PubMed]

| Parameter | Mean | SD | Minimum | Maximum |
|---|---|---|---|---|
| Age (years) | 44.0 | 23.2 | 1 | 95 |
| RBC (×106/mm3) | 5.94 | 0.58 | 5.00 | 7.41 |
| HB (g/dL) | 12.2 | 1.20 | 10.0 | 15.3 |
| HCT (%) | 38.6 | 3.83 | 31.9 | 49.3 |
| MCV (fL) | 64.9 | 3.13 | 57.4 | 70.9 |
| MCH (pg) | 20.5 | 1.06 | 17.8 | 22.6 |
| MCHC (%) | 31.5 | 0.66 | 30.3 | 33.2 |
| RDW-CV (%) | 14.5 | 0.79 | 13.0 | 18.0 |
| PLT (×103/mm3) | 291.3 | 75.94 | 130.0 | 493.0 |
| MPV (fL) | 9.2 | 0.82 | 7.6 | 12.3 |
| HbA2 (%) | 4.8 | 0.49 | 3.6 | 6.4 |
| Green & King index * | 50.64 | 6.25 | 36.2 | 68.5 |
| Country | Prevalence (%) | BTT Patients * | Sample Size | Characteristic of the Sample Population | Confirmatory Method | Ref. |
|---|---|---|---|---|---|---|
| Colombia | 18.4% | 409 | 2224 | Outpatient cohort (adults and children) | Hb ELP | [19] |
| Brazil | 1.00% | 87 | 8715 | Outpatient cohort (only adults) | HPLC | [20] |
| Chile | 0.06% | 11 | 18,206 | Outpatient cohort (only adults) | Hb ELP | [30] |
| Argentina | 1–2% | NR | NR | NR | NR | [41] |
| Venezuela | 1.48% | 1189 | 80,400 | Outpatient cohort (age not mentioned) | Hb ELP and HPLC | [42] |
| Peru | 2.50% | 130 | 5206 | Outpatient cohort (age not mentioned) | Hb ELP | [43] |
| Ecuador | 0.0% | 0 | 115 | Outpatient cohort (only adults) | Hb ELP | [44] |
| Uruguay | 0.25% | 1 | 397 | Outpatient cohort (only children) | Hb ELP and molecular confirmation | [45] |
| Test | IDA | ACD | BTT | α Thalassemia | BTT + IDA |
|---|---|---|---|---|---|
| Serum iron | Decreased | Normal/decreased | Normal | Normal | Decreased |
| TIBC | Increased | Normal/decreased | Normal | Normal | Increased |
| TSAT | Decreased | Normal/decreased | Normal | Normal | Decreased |
| Ferritin | Decreased | Increased | Normal | Normal | Decreased |
| HbA2 | Normal/decreased | Normal | Increased | Normal/decreased | Normal/decreased |
| HbF | Normal | Normal | Normal/increased | Normal | Normal/decreased/increased |
Disclaimer/Publisher’s Note: The statements, opinions and data contained in all publications are solely those of the individual author(s) and contributor(s) and not of MDPI and/or the editor(s). MDPI and/or the editor(s) disclaim responsibility for any injury to people or property resulting from any ideas, methods, instructions or products referred to in the content. |
© 2025 by the authors. Licensee MDPI, Basel, Switzerland. This article is an open access article distributed under the terms and conditions of the Creative Commons Attribution (CC BY) license (https://creativecommons.org/licenses/by/4.0/).
Share and Cite
Balcázar-Villarroel, M.; Mancilla-Uribe, A.; Navia-León, S.; Carrasco-Fajardin, L.; Bohle-Matamala, J.; Calbucura-Ovalle, C.; Torrens, F.; Carmine-Peña, E.; Sandoval, C.; Peña, F. Assessment of β-Thalassemia Trait Occurrence in an Outpatient Sample from Southern Chile: A Retrospective Study. Diagnostics 2025, 15, 2759. https://doi.org/10.3390/diagnostics15212759
Balcázar-Villarroel M, Mancilla-Uribe A, Navia-León S, Carrasco-Fajardin L, Bohle-Matamala J, Calbucura-Ovalle C, Torrens F, Carmine-Peña E, Sandoval C, Peña F. Assessment of β-Thalassemia Trait Occurrence in an Outpatient Sample from Southern Chile: A Retrospective Study. Diagnostics. 2025; 15(21):2759. https://doi.org/10.3390/diagnostics15212759
Chicago/Turabian StyleBalcázar-Villarroel, Mario, Angélica Mancilla-Uribe, Sandra Navia-León, Luis Carrasco-Fajardin, Johana Bohle-Matamala, Cristian Calbucura-Ovalle, Francisco Torrens, Eduardo Carmine-Peña, Cristian Sandoval, and Francisca Peña. 2025. "Assessment of β-Thalassemia Trait Occurrence in an Outpatient Sample from Southern Chile: A Retrospective Study" Diagnostics 15, no. 21: 2759. https://doi.org/10.3390/diagnostics15212759
APA StyleBalcázar-Villarroel, M., Mancilla-Uribe, A., Navia-León, S., Carrasco-Fajardin, L., Bohle-Matamala, J., Calbucura-Ovalle, C., Torrens, F., Carmine-Peña, E., Sandoval, C., & Peña, F. (2025). Assessment of β-Thalassemia Trait Occurrence in an Outpatient Sample from Southern Chile: A Retrospective Study. Diagnostics, 15(21), 2759. https://doi.org/10.3390/diagnostics15212759

